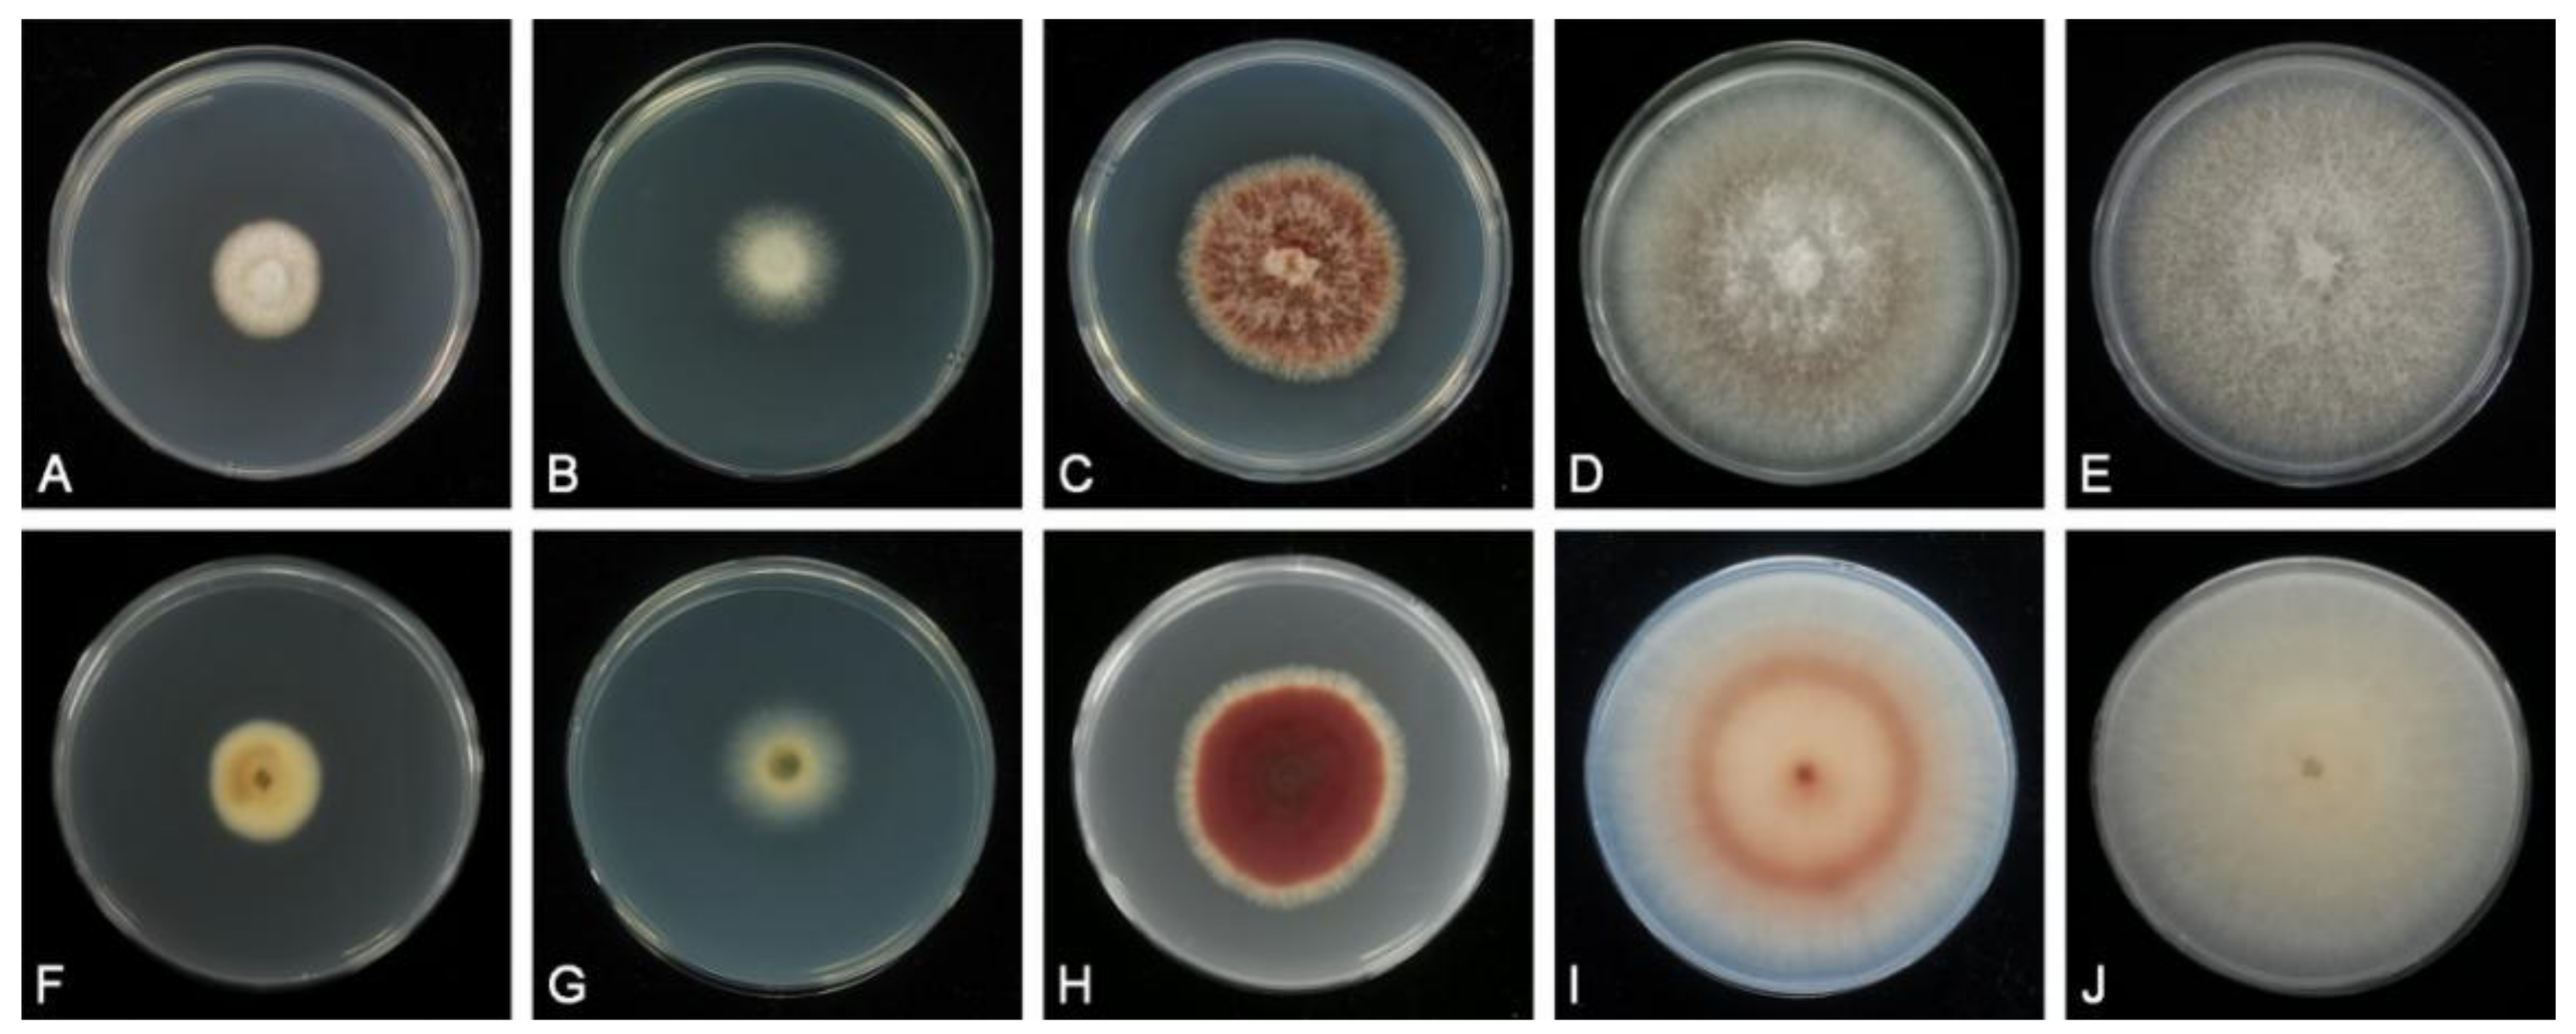
Jof 07 00563 g003

Phylogenetic Position of Shiraia-Like Endophytes on Bamboos and the Diverse Biosynthesis of Hypocrellin and Hypocrellin Derivatives
Abstract
:1. Introduction
2. Materials and Methods
2.1. Isolates
2.2. Morphological Analysis
2.3. DNA Extraction, PCR Amplification and Sequencing
2.4. Phylogenetic Analysis
2.5. Submerged Cultivation and Secondary Metabolite Extraction
2.6. HPLC-DAD-MS Analysis
3. Results
3.1. Phylogeny
3.2. Taxonomy
3.3. Hypocrellin Identification and Production
4. Discussion
5. Conclusions
Supplementary Materials
Author Contributions
Funding
Institutional Review Board Statement
Informed Consent Statement
Data Availability Statement
Conflicts of Interest
References
- Wan, X.Y.; Chen, Y.T. Hypocrellin A-A new drug for photochemotherapy. Chinese Sci. Bull. 1981, 26, 1040–1042. [Google Scholar]
- Ma, J.S.; Yan, F.; Wang, C.Q.; An, J.Y. Hypocrellin-A sensitized photoxidation of bilirubin. Photochem. Photobiol. 1989, 50, 827–830. [Google Scholar] [CrossRef] [PubMed]
- Ma, L.; Tai, H.; Li, C.; Zhang, Y.; Wang, Z.H.; Ji, W.Z. Photodynamic inhibitory effects of three perylenequinones on human colorectal carcinoma cell line and primate embryonic stem cell line. World J. Gastroenterol. 2003, 9, 485–490. [Google Scholar] [CrossRef] [PubMed]
- Ma, G.; Khan, S.I.; Jacob, M.R.; Tekwani, B.L.; Li, Z.; Pasco, D.S.; Walker, L.A.; Khan, I.A. Antimicrobial and antileishmanial activities of hypocrellins A and B. Antimicrob. Agents Chemother. 2004, 48, 4450–4452. [Google Scholar] [CrossRef] [Green Version]
- Deininger, M.H.; Weinschenk, T.; Morgalla, M.H.; Meyermann, R.; Schluesener, H.J. Release of regulators of angiogenesis following hypocrellin-A and -B photodynamic therapy of human brain tumor cells. Biochem. Bioph. Res. Commun. 2002, 298, 520–530. [Google Scholar] [CrossRef]
- Ali, S.M.; Chee, S.K.; Yuen, G.Y.; Olivo, M. Hypericin and hypocrellin induced apoptosis in human mucosal carcinoma cells. J. Photoch. Photobiol. B 2001, 65, 59–73. [Google Scholar] [CrossRef]
- Hudson, J.B.; Zhou, J.; Chen, J.; Harris, L.; Yip, L.; Towers, G.H.N. Hypocrellin, from Hypocrella bambuase, is phototoxic to human immunodeficiency virus. Photochem. Photobiol. 1994, 60, 253–255. [Google Scholar] [CrossRef]
- Liu, X.Y.; Shen, X.Y.; Fan, L.; Gao, J.; Hou, C.L. High-efficiency biosynthesis of hypocrellin A in Shiraia sp. using gamma-ray mutagenesis. Appl. Microbiol. Biotechnol. 2016, 100, 4875–4883. [Google Scholar] [CrossRef]
- Guo, L.Y.; Yan, S.Z.; Tao, X.; Yang, Q.; Li, Q.; Wang, T.S.; Yu, S.Q.; Chen, S.L. Evaluation of hypocrellin A-loaded lipase sensitive polymer micelles for intervening methicillin-resistant Staphylococcus Aureus antibiotic-resistant bacterial infection. Mater. Sci. Eng. C 2020, 106, 110230. [Google Scholar] [CrossRef]
- Wang, H.; Jia, Q.; Liu, W.; Nan, F.; Zheng, X.; Ding, Y.; Ren, H.; Wu, J.; Ge, J. Hypocrellin Derivative-Loaded Calcium Phosphate Nanorods as NIR Light-Triggered Phototheranostic Agents with Enhanced Tumor Accumulation for Cancer Therapy. ChemMedChem 2020, 15, 177–181. [Google Scholar] [CrossRef]
- Zheng, X.; Liu, W.; Ge, J.; Jia, Q.; Nan, F.; Ding, Y.; Wu, J.; Zhang, W.; Lee, C.S.; Wang, P. Biodegradable natural product-based nanoparticles for near-infrared fluorescence imaging-guided sonodynamic therapy. ACS Appl. Mater. Interfaces 2019, 11, 18178–18185. [Google Scholar] [CrossRef]
- Zhang, C.; Wu, J.; Liu, W.; Zheng, X.; Zhang, W.; Lee, C.S.; Wang, P. Hypocrellin-Based Multifunctional Phototheranostic Agent for NIR-Triggered Targeted Chemo/Photodynamic/Photothermal Synergistic Therapy against Glioblastoma. ACS Appl. Bio Mater. 2020, 3, 3817–3826. [Google Scholar] [CrossRef]
- Shen, X.Y.; Zheng, D.Q.; Gao, J.; Hou, C.L. Isolation and evaluation of endophytic fungi with antimicrobial ability from Phyllostachys edulis. Bangl. J. Pharmacol. 2012, 7, 249–257. [Google Scholar] [CrossRef] [Green Version]
- Su, Y.J.; Rao, S.Q.; Cai, Y.J.; Yang, Y.J. Preparation and characterization of the inclusion complex of hypocrellin A with hydroxypropyl-β-cyclodextrin. Eur. Food Res. Technol. 2010, 231, 781–788. [Google Scholar] [CrossRef]
- Su, Y.J.; Si, S.H.; Qiao, L.W.; Cai, Y.J.; Xu, Z.M.; Yang, Y.J. The effect of a hypocrellin A enriched diet on egg yolk quality and hypocrellin A distributions in the meat of laying hens. Eur. Food Res. Technol. 2011, 232, 935–940. [Google Scholar] [CrossRef]
- Al Subeh, Z.Y.; Raja, H.A.; Monro, S.; Flores-Bocanegra, L.; El-Elimat, T.; Pearce, C.J.; McFarland, S.A.; Oberlies, N.H. Enhanced production and anticancer properties of photoactivated perylenequinones. J. Nat. Prod. 2020, 83, 2490–2500. [Google Scholar] [CrossRef]
- Chen, W.X.; Cheng, Y.T.; Wan, X.Y.; Friedrichs, E.; Puff, H.; Breitmaier, E. Die Struktur des Hypocrellins und seines Photooxidationsproduktes Peroxyhypocrellin. Liebigs Ann. Chem. 1981, 1880–1885. [Google Scholar]
- Wan, X.Y.; Zhang, W.L.; Wang, Q.F. Isolation and identification of hypocrellin B from Hypocrella bambusae. J. Yunnan Univ. 1985, 4, 461–463. [Google Scholar]
- Zhang, M.H.; Chen, S.; An, J.Y.; Jiang, L.J. Separation and identification of hypocrellin B and fatty acids as ingredients in Hypocrella bambusae (B. et Br.) Sacc. Chin. Sci. Bull. 1989, 34, 1008–1014. [Google Scholar]
- Liu, B. Chinese Medicinal Fungi, 2nd ed.; Shanxi People’s Publishing House: Taiyuan, China, 1978; pp. 9–11. [Google Scholar]
- Wu, H.; Lao, X.F.; Wang, Q.W.; Lu, R.R.; Shen, C.; Zhang, F.; Liu, M.; Jia, L. The shiraiachromes: Novel fungal perylenequinone pigments from Shiraia bambusicola. J. Nat. Prod. 1989, 52, 948–951. [Google Scholar] [CrossRef]
- Kishi, T.; Tahara, S.; Taniguchi, N.; Tsuda, M.; Tanaka, C.; Takahashi, S. New perylenequinones from Shiraia bambusicola. Planta Med. 1991, 57, 376–379. [Google Scholar] [CrossRef]
- Fang, L.Z.; Qing, C.; Shao, H.J.; Yang, Y.D.; Dong, Z.J.; Wang, F.; Zhao, W.; Yang, W.Q.; Liu, J.K. Hypocrellin D, a cytotoxic fungal pigment from fruiting bodies of the ascomycete Shiraia bambusicola. J. Antibiot. 2006, 59, 351–354. [Google Scholar] [CrossRef]
- Liu, Y.X.; Hyde, K.D.; Ariyawansa, H.A.; Li, W.J.; Zhou, D.Q.; Yang, Y.L.; Chen, Y.M.; Liu, Z.Y. Shiraiaceae, new family of Pleosporales (Dothideomycetes, Ascomycota). Phytotaxa 2013, 103, 51–60. [Google Scholar] [CrossRef] [Green Version]
- Dai, D.Q.; Wijayawardene, N.N.; Tang, L.Z.; Liu, C.; Han, L.H.; Chu, H.L.; Wang, H.B.; Liao, C.F.; Yang, E.F.; Xu, R.F.; et al. Rubroshiraia gen. nov., a second hypocrellin-producing genus in Shiraiaceae (Pleosporales). MycoKeys 2019, 58, 1–26. [Google Scholar] [CrossRef] [Green Version]
- Morakotkarn, D.; Kawasaki, H.; Tanaka, K.; Okane, I.; Seki, T. Taxonomic characterization of Shiraia-like fungi isolated from bamboos in Japan. Mycoscience 2008, 49, 258–265. [Google Scholar] [CrossRef]
- Liang, X.H.; Cai, Y.J.; Liao, X.R.; Wu, K.; Wang, L.; Zhang, D.B.; Meng, Q. Isolation and identification of a new hypocrellin A-producing strain Shiraia sp. SUPER-H168. Microbiol. Res. 2009, 164, 9–17. [Google Scholar] [CrossRef]
- Zhang, M.; Pang, W.; Wang, J. Effect of oxidative stress on hypocrellin A yield in submerged cultures of endophytic Shiraia sp. A8. Planta Med. 2014, 80, P1N2. [Google Scholar] [CrossRef]
- Tong, Z.W.; Mao, L.; Liang, H.; Zhang, Z.; Wang, Y.; Yan, R.; Zhu, D. Simultaneous Determination of Six Perylenequinones in Shiraiaia sp. Slf14 by HPLC. J. Liq. Chromatogr. Relat. Technol. 2017, 40, 536–540. [Google Scholar] [CrossRef]
- Shen, X.Y.; Cheng, Y.L.; Cai, C.J.; Fan, L.; Gao, J.; Hou, C.L. Diversity and Antimicrobial Activity of Culturable Endophytic Fungi Isolated from Moso Bamboo Seeds. PLoS ONE 2014, 9, e95838. [Google Scholar] [CrossRef] [Green Version]
- Zhou, Y.K.; Shen, X.Y.; Hou, C.L. Diversity and antimicrobial activity of culturable fungi from fishscale bamboo (Phyllostachys Heteroclada) in China. World J. Microbiol. Biotechnol. 2017, 33, 104. [Google Scholar] [CrossRef]
- Liu, F.; Hu, D.M.; Cai, L. Conlarium duplumascospora gen. et. sp. nov. and Jobellisia guangdongensis sp. nov. from freshwater habitats in China. Mycologia 2012, 104, 1178–1186. [Google Scholar] [CrossRef] [PubMed] [Green Version]
- Gardes, M.; Bruns, T.D. ITS primers with enhanced specificity for basidiomycetes-application to the identification of mycorrhizae and rusts. Mol. Ecol. 1993, 2, 113–118. [Google Scholar] [CrossRef] [PubMed]
- White, T.J.; Bruns, T.D.; Lee, S.; Taylor, J. Amplification and Direct Sequencing of Fungal Ribosomal RNA Genes for Phylogenetics. In PCR Protocols: A Guide to Methods and Applications; Innis, M.A., Gelfand, D.H., Sninsky, J.J., Eds.; Academic Press: New York, NY, USA, 1990; pp. 315–322. [Google Scholar]
- Vilgalys, R.; Hester, M. Rapid genetic identification and mapping of enzymatically amplified ribosomal DNA from several Cryptococcus species. J. Bacteriol. 1990, 172, 4238–4246. [Google Scholar] [CrossRef] [PubMed] [Green Version]
- Rehner, S.A.; Buckley, E.A. Beauveria phylogeny inferred from nuclear ITS and EF1-α sequences: Evidence for cryptic diversification and links to Cordyceps teleomorphs. Mycologia 2005, 97, 84–98. [Google Scholar] [CrossRef] [PubMed]
- Liu, Y.J.; Whelen, S.; Hall, B.D. Phylogenetic relationships among ascomycetes: Evidence from an RNA polymerse II subunit. Mol. Biol. Evol. 1999, 16, 1799–1808. [Google Scholar] [CrossRef] [PubMed]
- Ariyawans, H.A.; Tsai, I.; Thambugala, K.M.; Chuang, W.Y.; Lin, S.R.; Hozzein, W.N.; Cheewangkoon, R. Species diversity of Pleosporalean taxa associated with Camellia sinensis (L.) Kuntze in Taiwan. Sci. Rep. UK 2020, 10, 12762. [Google Scholar] [CrossRef]
- Farris, J.S.; Källersjö, M.; Kluge, A.G.; Bult, C. Testing significance of incongruence. Cladistics-the international. J. Willi Hennig Soc. 1994, 10, 315–319. [Google Scholar] [CrossRef]
- Huelsenbeck, J.P.; Hillis, D.M.; Jones, R. Parametric Bootstrapping in Molecular Phylogenetics: Applications and Performance. In Molecular Zoology: Advances, Strategies and Protocols; Ferraris, J.D., Palumbi, S.R., Eds.; Wiley: New York, NY, USA, 1996; pp. 19–45. [Google Scholar]
- Swofford, D.L. Phylogenetic Analysis Using Parsimony (*and Other Methods), Version 4.0b10; Sinauer Associates: Sunderland, MA, USA, 2002. [Google Scholar]
- Ronquist, F.; Huelsenbeck, J.P. MrBayes 3: Bayesian phylogenetic inference under mixed models. Bioinformatics 2003, 19, 1572–1574. [Google Scholar] [CrossRef] [Green Version]
- Nylander, J.A.A. MrModeltest v2; Program Distributed by the Author; Evolutionary Biology Centre, Uppsala University: Uppsala, Sweden, 2004. [Google Scholar]
- Stamatakis, A.; Ludwig, T.; Meier, H. RAxML-III: A fast program for maximum likelihood-based inference of large phylogenetic trees. Bioinformatics 2005, 21, 456–463. [Google Scholar] [CrossRef] [Green Version]
- Stamatakis, A. RAxML-VI-HPC: Maximum likelihoodbased phylogenetic analyses with thousands of taxa and mixed models. Bioinformatics 2006, 22, 2688–2690. [Google Scholar] [CrossRef]
- Stamatakis, A. RAxML version 8: A tool for phylogenetic analysis and post-analysis of large phylogenies. Bioinformatics 2014, 30, 1312–1313. [Google Scholar] [CrossRef]
- Page, R.D.M. TreeView: An application to display phylogenetic trees on personal computers. Compu. Appl. Biosci. 1996, 12, 357–358. [Google Scholar]
- Niu, Y.; Wang, H.; Tong, X.; Li, X.; Guo, N.; Zhang, X.; Luo, Y.; Gao, Y.; He, T.; Lin, Z.; et al. Development of an on-line analytical platform to screen haptens in shuxuening injection based on high-performance liquid chromatography coupled with ion-trap multistage mass spectrometry and human serum albumin fluorescence detection. J. Chromatogr. A 2019, 1598, 232–241. [Google Scholar] [CrossRef]
- Cai, Y.; Liao, X.; Liang, X.; Ding, Y.; Sun, J.; Zhang, D. Induction of hypocrellin production by Triton X-100 under submerged fermentation with Shiraia sp. SUPER-H168. New Biotechnol. 2011, 28, 588–592. [Google Scholar] [CrossRef]
- Ma, Y.J.; Zheng, L.P.; Wang, J.W. Bacteria associated with Shiraia fruiting bodies influence fungal production of hypocrellin A. Front. Microbiol. 2019, 10, 2023. [Google Scholar] [CrossRef]
- Li, X.P.; Ma, Y.J.; Wang, J.W. Adding bamboo charcoal powder to Shiraia bambusicola preculture improves hypocrellin A production. Sustain. Chem. Pharm. 2019, 14, 100191. [Google Scholar] [CrossRef]
- Li, X.P.; Wang, Y.; Ma, Y.J.; Wang, J.W.; Zheng, L.P. Nitric Oxide and Hydrogen Peroxide Signaling in Extractive Shiraia Fermentation by Triton X-100 for Hypocrellin A Production. Int. J. Mol. Sci. 2020, 21, 882. [Google Scholar] [CrossRef] [Green Version]
- Hu, F.; Li, R.X.; Li, C.R.; Fan, M.Z. Hypocrellins produced by liquid fermentation of an anamorphic strain from Shiraia bambusicola. J. Biol. 2008, 25, 43–47. [Google Scholar]
- Du, W.; Liang, Z.; Zou, X.; Han, Y.; Liang, J.; Yu, J.; Chen, W.; Wang, Y.; Sun, C. Effects of microbial elicitor on production of hypocrellin by Shiraia bambusicola. Folia Microbiol. 2013, 58, 283–289. [Google Scholar] [CrossRef]
- Sun, C.X.; Ma, Y.J.; Wang, J.W. Enhanced production of hypocrellin A by ultrasound stimulation in submerged cultures of Shiraia bambusicola. Ultrason. Sonochem. 2017, 38, 214–224. [Google Scholar] [CrossRef]
- Yang, H.; Xiao, C.; Ma, W.; He, G. The production of hypocrellin colorants by submerged cultivation of the medicinal fungus Shiraia bambusicola. Dyes Pigments 2009, 82, 142–146. [Google Scholar] [CrossRef]
- Zhu, D.; Wang, J.; Zeng, Q.; Zhang, Z.; Yan, R. A novel endophytic Huperzine A–producing fungus, Shiraia sp. Slf14, isolated from Huperzia serrata. J. Appl. Microbiol. 2010, 109, 1469–1478. [Google Scholar] [CrossRef] [PubMed]
- Gao, R.; Xu, Z.; Deng, H.; Guan, Z.; Liao, X.; Zhao, Y.; Zheng, X.; Cai, Y. Influences of light on growth, reproduction and hypocrellin production by Shiraia sp. SUPER-H168. Arch. Microbiol. 2018, 200, 1217–1225. [Google Scholar] [CrossRef]
- Sun, C.X.; Ma, Y.J.; Wang, J.W. Improved hypocrellin A production in Shiraia bambusicola by light-dark shift. J. Photoch. Photobio. B Biol. 2018, 182, 100–107. [Google Scholar] [CrossRef]
- Ma, Y.J.; Zheng, L.P.; Wang, J.W. Inducing perylenequinone production from a bambusicolous fungus Shiraia sp. S9 through co-culture with a fruiting body-associated bacterium Pseudomonas Fulva SB1. Microb. Cell Fact. 2019, 18, 121. [Google Scholar] [CrossRef]
- Li, G.; Wang, H.; Zhu, R.; Sun, L.; Wang, L.; Li, M.; Li, Y.; Liu, Y.; Zhao, Z.; Lou, H. Phaeosphaerins A-F, Cytotoxic Perylenequinones from an Endolichenic Fungus, Phaeosphaeria sp. J. Nat. Prod. 2012, 75, 142–147. [Google Scholar] [CrossRef]
- Meng, L.; Sun, P.; Tang, H.; Li, L.; Draeger, S.; Schulz, B.; Krohn, K.; Hussain, H.; Zhan, W.; Yi, Y. Endophytic fungus Penicillium chrysogenum, a new source of hypocrellins. Biochem. Syst. Ecol. 2011, 39, 163–165. [Google Scholar] [CrossRef]

| Species | Specimen Voucher | Location | GenBank Accession Numbers | ||||
|---|---|---|---|---|---|---|---|
| ITS | LSU | SSU | TEF | RPB2 | |||
| Didymocyrtis banksiae | CBS 142523 * | Australia | KY979757 | KY979812 | — | — | KY979850 |
| Neoshiraia camelliae | NTUCC 18-092-1 * | China, Taiwan | MT112286 | MT071262 | MT071213 | MT743267 | MT513982 |
| NTUCC 18-092-2 | China, Taiwan | MT112287 | MT071263 | MT071214 | MT743268 | MT513981 | |
| Neoshiraia taiwanensis | NTUCC 17-031 * | China, Taiwan | MT112285 | MT071261 | MT071212 | MT114404 | MT743276 |
| NTUCC 18-091-5 | China, Taiwan | MT112280 | MT150600 | MT071207 | MT114405 | MT434762 | |
| NTUCC 18-091-6 | China, Taiwan | MT112309 | MT150602 | MT071236 | MT425440 | MT434766 | |
| NTUCC 18-091-7 | China, Taiwan | MT112310 | MT150601 | MT071237 | MT425441 | MT434765 | |
| Phaeosphaeria chiangraina | MFLUCC 13-0231 * | Thailand | KM434270 | KM434280 | KM434289 | KM434298 | KM434307 |
| Phaeosphaeria oryzae | CBS 110110 * | South Korea | KF251186 | KF251689 | GQ387530 | — | KF252193 |
| Phaeosphaeria sp. | 20081120 | China, Yunnan | HQ324780 | — | — | — | — |
| Pleospora herbarum | CBS 191.86 * | India | KC584239 | DQ247804 | GU238232 | DQ471090 | DQ247794 |
| Pleosporales sp. | MX286 | — | JQ905814 | — | — | — | — |
| Phaeosphaeriopsis agavacearum | CPC 29122 * | Australia | KY173430 | KY173520 | — | — | KY173591 |
| Poaceicola italica | MFLUCC 13-0267 | Italy | KX926421 | KX910094 | KX950409 | MG520924 | KX891169 |
| Populocrescentia forlicesesensis | MFLU 15-0651 * | — | KT306948 | KT306952 | KT306955 | MG520925 | — |
| Pseudoshiraia conidialis | zzz816 | China, Guangxi | HQ696072 | MZ519516 | HQ696106 | MZ516164 | MZ516177 |
| zzz510 | China, Guangxi | HQ696078 | MZ519517 | MZ519540 | MZ516165 | — | |
| CNUCC 0316 | China, Guangxi | MZ519529 | MZ519521 | MZ519536 | — | — | |
| CNUCC 0334 | China, Guangxi | MZ519528 | MZ519520 | MZ519535 | MZ516160 | — | |
| CNUCC 0019 | China, Guangxi | MZ519532 | MZ519523 | MZ519538 | MZ516162 | — | |
| CNUCC 0164 | China, Guangxi | MZ519530 | MZ519522 | MZ519537 | MZ516161 | MZ516175 | |
| CNUCC 1353PR * | China, Yunnan | MZ519527 | MZ519534 | MZ519533 | MZ516168 | — | |
| CNUCC 0006 | China, Anhui | MZ519531 | MZ519524 | MZ519539 | MZ516163 | MZ516176 | |
| JAP103846 | Japan | MZ519526 | MZ519519 | MZ519542 | MZ516167 | MZ516179 | |
| JAP103847 | Japan | MZ519525 | MZ519518 | MZ519541 | MZ516166 | MZ516178 | |
| JP93 | Japan | AB255277 | AB354975 | — | — | — | |
| JP256 | Japan | AB354995 | AB354980 | — | — | — | |
| JP232 | Japan | AB255303 | AB354979 | — | — | — | |
| JP7 | Japan | AB255241 | AB354974 | — | — | — | |
| SUPER H168 | China | EU267793 | — | EU267792 | — | — | |
| Rubroshiraia bambusae | HKAS102255 * | China | MK804678 | MK804658 | MK804704 | MK819218 | — |
| HKAS102256 | China | MK804679 | MK804659 | MK804705 | MK819219 | — | |
| HKAS102260 | China | MK804680 | MK804660 | MK804706 | MK819220 | — | |
| HKAS102268 | China | MK804681 | MK804661 | MK804707 | MK819221 | — | |
| HKAS102269 | China | MK804682 | MK804662 | MK804708 | MK819222 | — | |
| HKAS102270 | China | MK804683 | MK804663 | MK804709 | MK819223 | — | |
| HKAS102271 | China | MK804684 | MK804664 | MK804710 | MK819224 | — | |
| HKAS102272 | China | MK804685 | MK804665 | MK804711 | MK819225 | — | |
| HKAS102273 | China | MK804686 | MK804666 | MK804712 | MK819226 | — | |
| HKAS102274 | China | MK804687 | MK804667 | MK804713 | MK819227 | — | |
| BJTC HOU1000 | China, Yunnan | MZ497359 | MZ497374 | MZ497385 | MZ516169 | — | |
| CNUCC 1000 | China, Yunnan | MZ497360 | MZ497376 | MZ497387 | MZ516170 | MZ516180 | |
| Sclerostagonospora ericae | CPC 25927 * | South Africa | KX228268 | KX228319 | — | — | — |
| Shiraia bambusicola | HKAS102253 | China | MK804668 | MK804648 | MK804694 | MK819208 | MK819228 |
| HKAS102254 | China | MK804669 | MK804649 | MK804695 | MK819209 | MK819229 | |
| HKAS102257 | China | MK804670 | MK804650 | MK804696 | MK819210 | MK819230 | |
| HKAS102261 | China | MK804671 | MK804651 | MK804697 | MK819211 | MK819231 | |
| HKAS102262 | China | MK804672 | MK804652 | MK804698 | MK819212 | MK819232 | |
| HKAS102263 | China | MK804673 | MK804653 | MK804699 | MK819213 | MK819233 | |
| HKAS102264 | China | MK804674 | MK804654 | MK804700 | MK819214 | MK819234 | |
| HKAS102265 | China | MK804675 | MK804655 | MK804701 | MK819215 | MK819235 | |
| HKAS102266 | China | MK804676 | MK804656 | MK804702 | MK819216 | MK819236 | |
| HKAS102267 | China | MK804677 | MK804657 | MK804703 | MK819217 | MK819237 | |
| NBRC 30312 | Japan | AB354982 | AB354963 | ||||
| NBRC 30147 | Japan | AB354981 | AB354962 | ||||
| NBRC 30737 | Japan | AB354983 | AB354964 | ||||
| GZAAS2.0709 | China | GQ845413 | KC460983 | — | — | — | |
| GZAAS2.0629 | China | GQ845415 | KC460980 | — | — | — | |
| GZAAS2.0703 | China | GQ845412 | KC460981 | — | — | — | |
| GZAAS2.0708 * | China | GQ845414 | KC460982 | — | — | — | |
| BJTC HOU999 | China, Zhejiang | MZ497363 | MZ497378 | MZ497389 | MZ516171 | — | |
| CNUCC 122 | China, Zhejiang | MZ497367 | MZ497382 | MZ497391 | MZ516174 | — | |
| CNUCC 172 | China, Zhejiang | MZ497366 | MZ497381 | MZ497390 | MZ516173 | — | |
| CNUCC MJ1 | China, Zhejiang | MZ497365 | MZ497380 | MZ497392 | MZ516172 | — | |
| Shiraia sp. | JP151 | Japan | AB255289 | AB354977 | — | — | — |
| JP119 | Japan | AB354993 | AB354976 | — | — | — | |
| JP185 | Japan | AB354994 | AB354978 | — | — | — | |
| MSX60519 | — | MN970609 | — | — | — | — | |
| slf14 | — | GQ355934 | — | HM049630 | — | — | |
| Primer Pairs | Initial Step (T, t) | Denaturation (T, t) | Annealing (T, t) | Elongation (T, t) | Cycles | Final Step (T, t) |
|---|---|---|---|---|---|---|
| ITSIF/ITS4 | 94 °C, 5 min | 94 °C, 30 s | 55 °C, 30 s | 72 °C, 45 s | 35 | 72 °C, 10 min |
| LR0R/LR5 | 55 °C, 30 s | 72 °C, 90 s | ||||
| NS1/NS4 | 52 °C, 30 s | 72 °C, 90 s | ||||
| EF1-983F/EF1-2218R | 55 °C, 30 s | 72 °C, 60 s | ||||
| fRPB2-5f/fRPB2-7cr | 50 °C, 30 s | 72 °C, 80 s |
| Samples | HA | HB | SA | EA | EB | EC | Total Content |
|---|---|---|---|---|---|---|---|
| S. bambusicola BJTC HOU999 | 3.60 | 1.80 | 4.99 | 0.00 | 0.00 | 0.00 | 10.39 |
| R. bambusae BJTC HOU1000 | 49.54 | 6.02 | 10.34 | 0.00 | 0.00 | 0.00 | 65.89 |
| Samples | HA | HB | SA | EA | EB | EC | Total Content |
|---|---|---|---|---|---|---|---|
| zzz816 | 84.86 | 1.71 | 41.11 | 226.48 | 7.19 | 0.86 | 362.22 |
| CNUCC 1353PR | 677.11 | 155.36 | 152.31 | 326.59 | 60.41 | 38.36 | 1410.13 |
Publisher’s Note: MDPI stays neutral with regard to jurisdictional claims in published maps and institutional affiliations. |
© 2021 by the authors. Licensee MDPI, Basel, Switzerland. This article is an open access article distributed under the terms and conditions of the Creative Commons Attribution (CC BY) license (https://creativecommons.org/licenses/by/4.0/).
Share and Cite
Tong, X.; Wang, Q.-T.; Shen, X.-Y.; Hou, C.-L.; Cannon, P.F. Phylogenetic Position of Shiraia-Like Endophytes on Bamboos and the Diverse Biosynthesis of Hypocrellin and Hypocrellin Derivatives. J. Fungi 2021, 7, 563. https://doi.org/10.3390/jof7070563
Tong X, Wang Q-T, Shen X-Y, Hou C-L, Cannon PF. Phylogenetic Position of Shiraia-Like Endophytes on Bamboos and the Diverse Biosynthesis of Hypocrellin and Hypocrellin Derivatives. Journal of Fungi. 2021; 7(7):563. https://doi.org/10.3390/jof7070563
Chicago/Turabian StyleTong, Xin, Qiu-Tong Wang, Xiao-Ye Shen, Cheng-Lin Hou, and Paul F. Cannon. 2021. "Phylogenetic Position of Shiraia-Like Endophytes on Bamboos and the Diverse Biosynthesis of Hypocrellin and Hypocrellin Derivatives" Journal of Fungi 7, no. 7: 563. https://doi.org/10.3390/jof7070563
APA StyleTong, X., Wang, Q.-T., Shen, X.-Y., Hou, C.-L., & Cannon, P. F. (2021). Phylogenetic Position of Shiraia-Like Endophytes on Bamboos and the Diverse Biosynthesis of Hypocrellin and Hypocrellin Derivatives. Journal of Fungi, 7(7), 563. https://doi.org/10.3390/jof7070563

